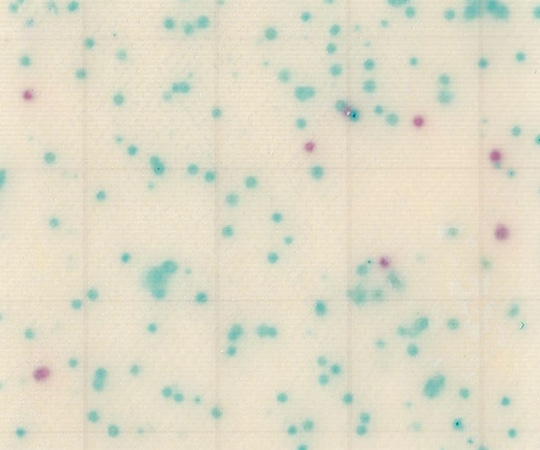
JNC MC-Media Pad EC 大腸菌・大腸菌群用 (100枚)　 1箱（ご注文単位1箱）【直送品】
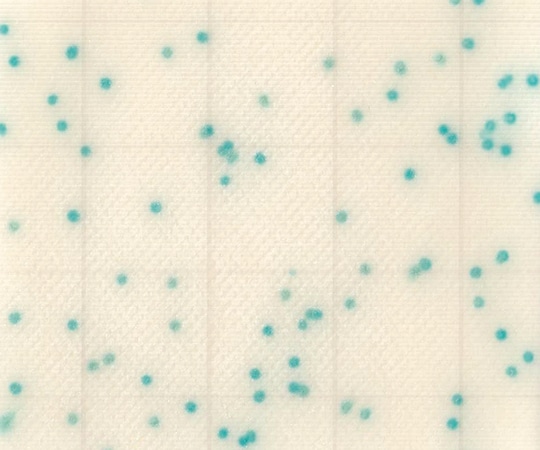
JNC MC-Media Pad CC 大腸菌群用 (100枚)　 1箱（ご注文単位1箱）【直送品】

培地のおすすめ人気ランキング
本ランキングは、シモジマオンラインの販売データをもとに、バイヤーの知見や市場トレンドを反映しています。
培地の人気商品や高評価の売れ筋アイテムをいち早くチェックできる、最新のおすすめランキングです。
Merck クリーンルーム用環境測定培地 1ケース(20枚入) SCD ICR90 1ケース(ご注文単位1ケース)【直送品】
培地
●耐乾燥性に優れ、培地表面がひび割れにくいです。●アイソレーター及びクリーンルーム対応です。●3重包装で、内袋にはガス滅菌用の吊り穴が付いています。●ICR●内容量:30mL●γ線滅菌済●※保存方法:2~25℃(常温)●型番:SCD ICR90●こちらの商品は事業者様向け商品です。
- 商品コード:
- 2500100021656
島津ダイアグノスティクス コンパクトドライ EC(大腸菌・大腸菌群数測定用) 4枚×10袋 06742 1箱(ご注文単位1箱)【直送品】
培地
●培地調製の不要な菌数測定用の培地です。●AOAC PTM(性能検証済み試験法)を取得しています。●接種した試料液は自然に均一に拡散します。●発育した集落は着色するため菌数の計測が容易です。●発育集落の釣菌が可能です。●●スマホでのコンパクトドライ専用コロニーカウントサービス「@BactLAB」を提供しています。詳細は「図面・資料」の案内をご確認ください。●γ線滅菌済(一括包装)●大腸菌|大腸菌群数測定用●入数:1箱(4枚/袋×10袋入)●※保存方法:1~30℃(常温)●※有効期限:製造より24ヶ月●※食品衛生検査指針 微生物編2018収載製品●こちらの商品は事業者様向け商品です。
- 商品コード:
- 2500100092632
島津ダイアグノスティクス コンパクトドライ (黄色ブドウ球菌測定用/4枚×10袋) 06729 1箱(ご注文単位1箱)【直送品】
培地
●培地調製の不要な菌数測定用の培地です。●AOAC PTM(性能検証済み試験法)を取得しています。●接種した試料液は自然に均一に拡散します。●発育した集落は着色するため菌数の計測が容易です。●発育集落の釣菌が可能です。●●スマホでのコンパクトドライ専用コロニーカウントサービス「@BactLAB」を提供しています。詳細は「図面・資料」の案内をご確認ください。●γ線滅菌済(一括包装)●黄色ブドウ球菌測定用●入数:1箱(4枚/袋×10袋入)●※保存方法:1~30℃(常温)●※有効期限:製造より24ヶ月●※食品衛生検査指針 微生物編2018収載製品●こちらの商品は事業者様向け商品です。
- 商品コード:
- 2500100092649
島津ダイアグノスティクス コンパクトドライ SL(サルモネラ属菌測定用) 4枚×10袋 06732 1箱(ご注文単位1箱)【直送品】
培地
●培地調製の不要な菌数測定用の培地です。●AOAC PTM(性能検証済み試験法)を取得しています。●接種した試料液は自然に均一に拡散します。●発育した集落は着色するため菌数の計測が容易です。●発育集落の釣菌が可能です。●●スマホでのコンパクトドライ専用コロニーカウントサービス「@BactLAB」を提供しています。詳細は「図面・資料」の案内をご確認ください。●γ線滅菌済(一括包装)●サルモネラ検出用●入数:1箱(4枚/袋×10袋入)●※保存方法:1~30℃(常温)●※有効期限:製造より18ヶ月●こちらの商品は事業者様向け商品です。
- 商品コード:
- 2500100092656
島津ダイアグノスティクス コンパクトドライ (セレウス菌検出用/4枚×10袋) 06533 1箱(ご注文単位1箱)【直送品】
培地
●培地調製の不要な菌数測定用の培地です。●MicroValを取得しています。●接種した試料液は自然に均一に拡散します。●発育した集落は着色するため菌数の計測が容易です。●発育集落の釣菌が可能です。●γ線滅菌済(一括包装)●セレウス菌検出用●入数:1箱(4枚/袋×10袋入)●※保存方法:1~30℃(常温)●※有効期限:製造より18ヶ月●こちらの商品は事業者様向け商品です。
- 商品コード:
- 2500100092663
島津ダイアグノスティクス コンパクトドライ (黄色ブドウ球菌測定用/4枚×60袋) 06730 1箱(ご注文単位1箱)【直送品】
培地
●培地調製の不要な菌数測定用の培地です。●AOAC PTM(性能検証済み試験法)を取得しています。●接種した試料液は自然に均一に拡散します。●発育した集落は着色するため菌数の計測が容易です。●発育集落の釣菌が可能です。●●スマホでのコンパクトドライ専用コロニーカウントサービス「@BactLAB」を提供しています。詳細は「図面・資料」の案内をご確認ください。●γ線滅菌済(一括包装)●黄色ブドウ球菌測定用●入数:1箱(4枚/袋×60袋入)●※保存方法:1~30℃(常温)●※有効期限:製造より24ヶ月●※食品衛生検査指針 微生物編2018収載製品●こちらの商品は事業者様向け商品です。
- 商品コード:
- 2500100198716
島津ダイアグノスティクス コンパクトドライ (一般生菌数測定用/4枚×60袋) 06741 1箱(ご注文単位1箱)【直送品】
培地
●培地調製の不要な菌数測定用の培地です。●AOAC PTM(性能検証済み試験法)を取得しています。●接種した試料液は自然に均一に拡散します。●発育した集落は着色するため菌数の計測が容易です。●発育集落の釣菌が可能です。●●スマホでのコンパクトドライ専用コロニーカウントサービス「@BactLAB」を提供しています。詳細は「図面・資料」の案内をご確認ください。●γ線滅菌済(一括包装)●一般生菌数測定用●入数:1箱(4枚/袋×60袋入)●※保存方法:1~30℃(常温)●※有効期限:製造より24ヶ月●※食品衛生検査指針 微生物編2018収載製品●こちらの商品は事業者様向け商品です。
- 商品コード:
- 2500100198747
サン化学 滅菌計量棒 1袋(100本入) 14 1袋(ご注文単位1袋)【直送品】
培地
●検体の採取|希釈の際に使用し、1mLの位置に目盛が付いています。●★長さ18㎝直径5㎜●★滅菌サンパックとサンコリ検体作製水を使うことで希釈倍率を行えます●★日本製●滅菌計量棒●入数:1袋(100本入)●こちらの商品は事業者様向け商品です。
- 商品コード:
- 2500100245649
JNC MC-Media Pad YM 真菌(カビ・酵母)用(100枚) 1箱(ご注文単位1箱)【直送品】
培地
●手軽にかつ正確な微生物検査が可能です。●サンプルを培地パッドに滴下するだけですので、不慣れな方でも取り扱いが容易です。●経験の差が出にくくなります。●発育した菌は特徴的な発色コロニーを形成しますので、判定が容易です。●運動性の高い菌も計測しやすく、判定に経験の差が出にくくなっています。●滅菌された出来合い培地ですので、培地調製が不要です。●食材等の試料液検査をはじめスタンプ法・塗抹法・メンブランフィルター法・落下菌の検査が可能です。●かさばらず、長期保存が可能です。●省スペース化と廃棄量低減により、環境にやさしい製品です。●国際認証 MicroVal、AOAC OMA、AOAC PTM 認証取得●食品衛生検査指針収載●対象菌:真菌(カビ・酵母)●入数:1箱(25枚/袋×4袋入)●培養条件:25℃ 48-72時間●保存方法:2-15℃の冷蔵庫●アルミ袋開封後、未使用のシート培地はアルミ袋にシールして冷蔵保管●★MicroVal認証No.:2015LR51●★AOC OMA認証No.:2018.02●こちらの商品は事業者様向け商品です。
- 商品コード:
- 2500100309471
JNC MC-Media Pad EC 大腸菌・大腸菌群用 (100枚) 1箱(ご注文単位1箱)【直送品】
培地
●手軽にかつ正確な微生物検査が可能です。●サンプルを培地パッドに滴下するだけですので、不慣れな方でも取り扱いが容易です。●経験の差が出にくくなります。●発育した菌は特徴的な発色コロニーを形成しますので、判定が容易です。●運動性の高い菌も計測しやすく、判定に経験の差が出にくくなっています。●滅菌された出来合い培地ですので、培地調製が不要です。●食材等の試料液検査をはじめスタンプ法・塗抹法・メンブランフィルター法・落下菌の検査が可能です。●かさばらず、長期保存が可能です。●省スペース化と廃棄量低減により、環境にやさしい製品です。●国際認証 MicroVal、AOAC PTM 認証取得●食品衛生検査指針収載●対象菌:大腸菌及び大腸菌群●入数:1箱(25枚/袋×4袋入)●培養条件:35℃ 24時間●保存方法:2-15℃の冷蔵庫●アルミ袋開封後、未使用のシート培地はアルミ袋にシールして冷蔵保管●★※「食品衛生検査指針 微生物編2018」収載製品●★MicroVal認証No.:2017LR71●★AOAC PTM認証No.:011902●こちらの商品は事業者様向け商品です。
- 商品コード:
- 2500100309495
プロラボ マイクロバンク 1個(25本入) 25 1個(ご注文単位1個)【直送品】
培地
●菌株保存用バイアル●便利な小包装25バイアル入●入数:25本●容器サイズ:76x76x52(mm)●重量:185g●色:5色ミックス(各5本)●コード番号:019100593●こちらの商品は事業者様向け商品です。
- 商品コード:
- 2500100054661
島津ダイアグノスティクス コンパクトドライ (大腸菌|大腸菌群数測定用/4枚×60袋) 06743 1箱(ご注文単位1箱)【直送品】
培地
●培地調製の不要な菌数測定用の培地です。●AOAC PTM(性能検証済み試験法)を取得しています。●接種した試料液は自然に均一に拡散します。●発育した集落は着色するため菌数の計測が容易です。●発育集落の釣菌が可能です。●●スマホでのコンパクトドライ専用コロニーカウントサービス「@BactLAB」を提供しています。詳細は「図面・資料」の案内をご確認ください。●γ線滅菌済(一括包装)●大腸菌|大腸菌群数測定用●入数:1箱(4枚/袋×60袋入)●※保存方法:1~30℃(常温)●※有効期限:製造より24ヶ月●※食品衛生検査指針 微生物編2018収載製品●こちらの商品は事業者様向け商品です。
- 商品コード:
- 2500100198709
島津ダイアグノスティクス コンパクトドライ (サルモネラ検出用/4枚×60袋) 06733 1箱(ご注文単位1箱)【直送品】
培地
●培地調製の不要な菌数測定用の培地です。●AOAC PTM(性能検証済み試験法)を取得しています。●接種した試料液は自然に均一に拡散します。●発育した集落は着色するため菌数の計測が容易です。●発育集落の釣菌が可能です。●●スマホでのコンパクトドライ専用コロニーカウントサービス「@BactLAB」を提供しています。詳細は「図面・資料」の案内をご確認ください。●γ線滅菌済(一括包装)●サルモネラ検出用●入数:1箱(4枚/袋×60袋入)●※保存方法:1~30℃(常温)●※有効期限:製造より18ヶ月●こちらの商品は事業者様向け商品です。
- 商品コード:
- 2500100198723
島津ダイアグノスティクス コンパクトドライ (大腸菌群数測定用/4枚×60袋) 06745 1箱(ご注文単位1箱)【直送品】
培地
●培地調製の不要な菌数測定用の培地です。●AOAC|PTM(性能検証済み試験法)を取得しています。●接種した試料液は自然に均一に拡散します。●発育した集落は着色するため菌数の計測が容易です。●発育集落の釣菌が可能です。●●スマホでのコンパクトドライ専用コロニーカウントサービス「@BactLAB」を提供しています。詳細は「図面・資料」の案内をご確認ください。●γ線滅菌済(一括包装)●大腸菌群数測定用●入数:1箱(4枚/袋×60袋入)●※保存方法:1~30℃(常温)●※有効期限:製造より24ヶ月●※食品衛生検査指針 微生物編2018収載製品●こちらの商品は事業者様向け商品です。
- 商品コード:
- 2500100198730
島津ダイアグノスティクス コンパクトドライ (腸炎ビブリオ測定用/4枚×60袋) 06749 1箱(ご注文単位1箱)【直送品】
培地
●培地調製の不要な菌数測定用の培地です。●AOAC PTM(性能検証済み試験法)を取得しています。●接種した試料液は自然に均一に拡散します。●発育した集落は着色するため菌数の計測が容易です。●発育集落の釣菌が可能です。●●スマホでのコンパクトドライ専用コロニーカウントサービス「@BactLAB」を提供しています。詳細は「図面・資料」の案内をご確認ください。●γ線滅菌済(一括包装)●腸炎ビブリオ測定用●入数:1箱(4枚/袋×60袋入)●※保存方法:1~30℃(常温)●※有効期限:製造より18ヶ月●こちらの商品は事業者様向け商品です。
- 商品コード:
- 2500100198754
島津ダイアグノスティクス コンパクトドライ (セレウス菌検出用/4枚×60袋) 06534 1箱(ご注文単位1箱)【直送品】
培地
●培地調製の不要な菌数測定用の培地です。●MicroValを取得しています。●接種した試料液は自然に均一に拡散します。●発育した集落は着色するため菌数の計測が容易です。●発育集落の釣菌が可能です。●γ線滅菌済(一括包装)●セレウス菌検出用●入数:1箱(4枚/袋×60袋入)●※保存方法:1~30℃(常温)●※有効期限:製造より18ヶ月●こちらの商品は事業者様向け商品です。
- 商品コード:
- 2500100198761
JNC MC-Media Pad サルモネラ用 (100枚) 1箱(ご注文単位1箱)【直送品】
培地
●手軽にかつ正確な微生物検査が可能です。●サンプルを培地パッドに滴下するだけですので、不慣れな方でも取り扱いが容易です。●経験の差が出にくくなります。●発育した菌は特徴的な発色コロニーを形成しますので、判定が容易です。●運動性の高い菌も計測しやすく、判定に経験の差が出にくくなっています。●滅菌された出来合い培地ですので、培地調製が不要です。●食材等の試料液検査をはじめスタンプ法・塗抹法・メンブランフィルター法・落下菌の検査が可能です。●かさばらず、長期保存が可能です。●省スペース化と廃棄量低減により、環境にやさしい製品です。●国際認証取得準備中●対象菌:サルモネラ●入数:1箱(25枚/袋×4袋入)●培養条件:35℃ 24時間●保存方法:2-15℃の冷蔵庫●アルミ袋開封後、未使用のシート培地はアルミ袋にシールして冷蔵保管●こちらの商品は事業者様向け商品です。
- 商品コード:
- 2500100309464
JNC MC-Media Pad CC 大腸菌群用 (100枚) 1箱(ご注文単位1箱)【直送品】
培地
●手軽にかつ正確な微生物検査が可能です。●サンプルを培地パッドに滴下するだけですので、不慣れな方でも取り扱いが容易です。●経験の差が出にくくなります。●発育した菌は特徴的な発色コロニーを形成しますので、判定が容易です。●運動性の高い菌も計測しやすく、判定に経験の差が出にくくなっています。●滅菌された出来合い培地ですので、培地調製が不要です。●食材等の試料液検査をはじめスタンプ法・塗抹法・メンブランフィルター法・落下菌の検査が可能です。●かさばらず、長期保存が可能です。●省スペース化と廃棄量低減により、環境にやさしい製品です。●国際認証 MicroVal、AOAC PTM 認証取得●食品衛生検査指針収載●対象菌:大腸菌群●入数:1箱(25枚/袋×4袋入)●培養条件:35℃ 24時間●保存方法:2-15℃の冷蔵庫●アルミ袋開封後、未使用のシート培地はアルミ袋にシールして冷蔵保管●★※「食品衛生検査指針 微生物編2018」収載製品●★MicroVal認証No.:2017LR70●★AOAC PTM認証No.:011901●こちらの商品は事業者様向け商品です。
- 商品コード:
- 2500100309488
JNC MC-Media Pad 一般生菌用 (1000枚) 1ケース(ご注文単位1ケース)【直送品】
培地
●手軽にかつ正確な微生物検査が可能です。●サンプルを培地パッドに滴下するだけですので、不慣れな方でも取り扱いが容易です。●経験の差が出にくくなります。●発育した菌は特徴的な発色コロニーを形成しますので、判定が容易です。●運動性の高い菌も計測しやすく、判定に経験の差が出にくくなっています。●滅菌された出来合い培地ですので、培地調製が不要です。●食材等の試料液検査をはじめスタンプ法・塗抹法・メンブランフィルター法・落下菌の検査が可能です。●かさばらず、長期保存が可能です。●省スペース化と廃棄量低減により、環境にやさしい製品です。●国際認証 AOAC PTM 認証取得●食品衛生検査指針収載●対象菌:一般生菌●入数:1ケース(10箱入)(※1箱あたりに、25枚/袋×4袋が入っています)●培養条件:35℃ 48時間●保存方法:2-15℃の冷蔵庫●アルミ袋開封後、未使用のシート培地はアルミ袋にシールして冷蔵保管●★※「食品衛生検査指針 微生物編2018」収載製品●★AOAC PTM認証No.:011001●こちらの商品は事業者様向け商品です。
- 商品コード:
- 2500100309501
島津ダイアグノスティクス コンパクトドライ (大腸菌群数測定用/4枚×10袋) 06744 1箱(ご注文単位1箱)【直送品】
培地
●培地調製の不要な菌数測定用の培地です。●AOAC PTM(性能検証済み試験法)を取得しています。●接種した試料液は自然に均一に拡散します。●発育した集落は着色するため菌数の計測が容易です。●発育集落の釣菌が可能です。●●スマホでのコンパクトドライ専用コロニーカウントサービス「@BactLAB」を提供しています。詳細は「図面・資料」の案内をご確認ください。●γ線滅菌済(一括包装)●大腸菌群数測定用●入数:1箱(4枚/袋×10袋入)●※保存方法:1~30℃(常温)●※有効期限:製造より24ヶ月●※食品衛生検査指針 微生物編2018収載製品●こちらの商品は事業者様向け商品です。
- 商品コード:
- 2500100361646
島津ダイアグノスティクス コンパクトドライ TC(生菌数測定用)4枚×10袋 06740 1箱(ご注文単位1箱)【直送品】
培地
●培地調製の不要な菌数測定用の培地です。●AOAC PTM(性能検証済み試験法)を取得しています。●接種した試料液は自然に均一に拡散します。●発育した集落は着色するため菌数の計測が容易です。●発育集落の釣菌が可能です。●●スマホでのコンパクトドライ専用コロニーカウントサービス「@BactLAB」を提供しています。詳細は「図面・資料」の案内をご確認ください。●γ線滅菌済(一括包装)●一般生菌数測定用●入数:1箱(4枚/袋×10袋入)●※保存方法:1~30℃(常温)●※有効期限:製造より24ヶ月●※食品衛生検査指針 微生物編2018収載製品●こちらの商品は事業者様向け商品です。
- 商品コード:
- 2500100361653
島津ダイアグノスティクス コンパクトドライ (酵母|カビ測定用/4枚×10袋) 06746 1箱(ご注文単位1箱)【直送品】
培地
●培地調製の不要な菌数測定用の培地です。●AOAC PTM(性能検証済み試験法)を取得しています。●接種した試料液は自然に均一に拡散します。●発育した集落は着色するため菌数の計測が容易です。●発育集落の釣菌が可能です。●●スマホでのコンパクトドライ専用コロニーカウントサービス「@BactLAB」を提供しています。詳細は「図面・資料」の案内をご確認ください。●γ線滅菌済(一括包装)●酵母|カビ測定用●入数:1箱(4枚/袋×10袋入)●※保存方法:1~30℃(常温)●※有効期限:製造より18ヶ月●こちらの商品は事業者様向け商品です。
- 商品コード:
- 2500100361660
島津ダイアグノスティクス コンパクトドライ (腸炎ビブリオ測定用/4枚×10袋) 06748 1箱(ご注文単位1箱)【直送品】
培地
●培地調製の不要な菌数測定用の培地です。●AOAC PTM(性能検証済み試験法)を取得しています。●接種した試料液は自然に均一に拡散します。●発育した集落は着色するため菌数の計測が容易です。●発育集落の釣菌が可能です。●●スマホでのコンパクトドライ専用コロニーカウントサービス「@BactLAB」を提供しています。詳細は「図面・資料」の案内をご確認ください。●γ線滅菌済(一括包装)●腸炎ビブリオ測定用●入数:1箱(4枚/袋×10袋入)●※保存方法:1~30℃(常温)●※有効期限:製造より18ヶ月●こちらの商品は事業者様向け商品です。
- 商品コード:
- 2500100361677
島津ダイアグノスティクス コンパクトドライ ETB(腸内細菌科細菌群数測定用) 4枚×10袋 06535 1箱(ご注文単位1箱)【直送品】
培地
●培地調製の不要な菌数測定用の培地です。●AOAC PTM(性能検証済み試験法)を取得しています。●接種した試料液は自然に均一に拡散します。●発育した集落は着色するため菌数の計測が容易です。●発育集落の釣菌が可能です。●γ線滅菌済(一括包装)●腸内細菌科細菌群数測定用●入数:1箱(4枚/袋×10袋入)●※保存方法:1~30℃(常温)●※有効期限:製造より16ヶ月、その他/製造より18ヶ月●こちらの商品は事業者様向け商品です。
- 商品コード:
- 2500100361684
島津ダイアグノスティクス コンパクトドライ (酵母|カビ測定用/4枚×60袋) 06747 1箱(ご注文単位1箱)【直送品】
培地
●培地調製の不要な菌数測定用の培地です。●AOAC PTM(性能検証済み試験法)を取得しています。●接種した試料液は自然に均一に拡散します。●発育した集落は着色するため菌数の計測が容易です。●発育集落の釣菌が可能です。●●スマホでのコンパクトドライ専用コロニーカウントサービス「@BactLAB」を提供しています。詳細は「図面・資料」の案内をご確認ください。●γ線滅菌済(一括包装)●酵母|カビ測定用●入数:1箱(4枚/袋×60袋入)●※保存方法:1~30℃(常温)●※有効期限:製造より18ヶ月●こちらの商品は事業者様向け商品です。
- 商品コード:
- 2500100361691
ベクトン・ディッキンソン BD Bacto(TM) ブレインハートインフュージョン 500g 237500 1個(ご注文単位1個)【直送品】
培地
●レンサ球菌、肺炎球菌および髄膜炎菌等の培養条件の難しい微生物の培養に用います。●粉末培地●用途:一般細菌用●質量:500g●こちらの商品は事業者様向け商品です。
- 商品コード:
- 2500100365880
ベクトン・ディッキンソン BD Difco(TM) マリンアガー2216 212185 1個(ご注文単位1個)【直送品】
培地
次回の入荷は未定です
●従属栄養海洋性細菌の分離、培養および菌数測定用です。●粉末培地●用途:従属栄養細菌用●質量:500g●こちらの商品は事業者様向け商品です。
- 商品コード:
- 2500100365897
価格: 33,136円(税込)
サン化学 サンコリ簡易菌検出紙 (大腸菌群用)1箱(100枚入) 00001 1箱(ご注文単位1箱)【直送品】
培地
●検出紙に検液を浸し、35~37℃で24時間培養するだけの簡易型菌検出紙です。●★大腸菌群がいた場合は、赤色斑点が出ます。●★検体が水溶性なら直接検出紙を浸して培養できます。●★サン滅菌綿棒とサンコリ検体作製水を使う事で拭き取り検査もできます。●★滅菌サンパックとサンコリ検体作製水を使う事で食材などの食材(固形物)の検査もできます。●★培養後、検出紙に消毒用アルコールをかける事で菌が増えずに資料として保管ができます。●★日本製●サイズ:123×20mm●EOG滅菌済●検出紙(大腸菌群用)●入数:1箱(100枚入)●培養方法:35~37℃|24時間培養●※保存方法:冷暗所●こちらの商品は事業者様向け商品です。
- 商品コード:
- 2500100400833
サン化学 サンコリ簡易菌検出紙 (一般細菌用)1箱(100枚入) 00003 1箱(ご注文単位1箱)【直送品】
培地
●検出紙に検液を浸し、35~37℃で24時間培養するだけの簡易型菌検出紙です。●★一般細菌がいた場合は、赤色斑点が出ます。●★検体が水溶性なら直接検出紙を浸して培養できます。●★サン滅菌綿棒とサンコリ検体作製水を使う事で拭き取り検査もできます。●★滅菌サンパックとサンコリ検体作製水を使う事で食材などの食材(固形物)の検査もできます。●★培養後、検出紙に消毒用アルコールをかける事で菌が増えずに資料として保管ができます。●★日本製●サイズ:123×20mm●EOG滅菌済●検出紙(一般細菌用)●入数:1箱(100枚入)●培養方法:35~37℃|24時間培養●※保存方法:冷暗所●こちらの商品は事業者様向け商品です。
- 商品コード:
- 2500100400857
サン化学 簡易菌検出紙 (大腸菌群XTYPE)1箱(100枚入) 00006 1箱(ご注文単位1箱)【直送品】
培地
●検出紙に検液を浸し、35~37℃で24時間培養するだけの簡易型菌検出紙です。●培養後紫外線を照射するとE.coliのみ蛍光発色します。●★大腸菌群がいた場合は、青色斑点が出ます。●★紫外線照射をして青色斑点が蛍光発色したものが大腸菌になります。●★検体が水溶性なら直接検出紙を浸して培養できます。●★サン滅菌綿棒とサンコリ検体作製水を使う事で拭き取り検査もできます。●★滅菌サンパックとサンコリ検体作製水を使う事で食材などの食材(固形物)の検査もできます。●★培養後、検出紙に消毒用アルコールをかける事で菌が増えずに資料として保管ができます。●★日本製●サイズ:123×20mm●EOG滅菌済●検出紙(大腸菌群用)(X-TYPE)●入数:1箱(100枚入)●培養方法:35~37℃|24時間培養●※保存方法:冷暗所●こちらの商品は事業者様向け商品です。
- 商品コード:
- 2500100400871
サン化学 滅菌サンパック 1袋(100枚入) 12 1袋(ご注文単位1袋)【直送品】
培地
●滅菌済でディスポタイプのビニール袋です。●★チャック袋長さ16㎝(チャック下14㎝)幅5cm●★ビーカーの代わりに使用します●★滅菌計量棒とサンコリ検体作製水を使うことで希釈倍率を行えます●★検食の小分け袋としても使えます●★日本製●滅菌サンパック●入数:1袋(100枚入)●こちらの商品は事業者様向け商品です。
- 商品コード:
- 2500100400895
島津ダイアグノスティクス コンパクトドライ YMR(カビ・酵母迅速測定用) 40枚 06777 1箱(ご注文単位1箱)【直送品】
培地
●培地調製のいらない菌数測定用の培地です。●用途:酵母・カビ迅速測定用●●スマホでのコンパクトドライ専用コロニーカウントサービス「@BactLAB」を提供しています。詳細は「図面・資料」の案内をご確認ください。●入数:40枚●重量:505g●※保存方法:1~30℃(常温)●※有効期限:製造より18ヶ月●こちらの商品は事業者様向け商品です。
- 商品コード:
- 2500100443144
島津ダイアグノスティクス アキュディア TGC培地(顆粒)「ニッスイ」 (チオグリコレート培地) 300g 05601 1本(ご注文単位1本)【直送品】
培地
●日本薬局方準拠培地●無菌試験用●内容量:300g●重量:438g●※保存方法:室温・防湿●※有効期限:製造より3年●こちらの商品は事業者様向け商品です。
- 商品コード:
- 2500100443151
栄研化学 ぺたんチェックRDD DD寒天培地 1箱(20枚入) PD0001 1箱(ご注文単位1箱)【直送品】
培地
●ぺたんと押して微生物チェックします。●特定の汚染菌の有無を選択的に確認できます。●一般細菌検出用培地は最短8時間で判定が可能です(発色液を使用)。●品名:DD寒天培地●使用目的:一般細菌検出用●測定する集落:発育したすべての赤色集落(発色液使用)●入数:1箱(20枚入)●培地表面積:10cm2●こちらの商品は事業者様向け商品です。
- 商品コード:
- 2500100443526
極東製薬工業 プレメディアミルピーNo2培地 100g 02680 1本(ご注文単位1本)【直送品】
培地
●乳中の残留抗菌性物質試験用●培地を溶媒に接触させない「乾式造粒法」を採用、色調、pHの変化等培地本来の性能の劣化がありません。●顆粒●こちらの商品は事業者様向け商品です。
- 商品コード:
- 2500100536761
極東製薬工業 プレメディアミルピーNo3培地 100g 02690 1本(ご注文単位1本)【直送品】
培地
●乳中の残留抗菌性物質試験用●培地を溶媒に接触させない「乾式造粒法」を採用、色調、pHの変化等培地本来の性能の劣化がありません。●顆粒●こちらの商品は事業者様向け商品です。
- 商品コード:
- 2500100536778
極東製薬工業 プレメディアノボビオシン加mEC培地 450mL用×61 1箱(61包入) 02847 1箱(ご注文単位1箱)【直送品】
培地
●腸管出血性大腸菌O157選択増菌培地●培地を溶媒に接触させない「乾式造粒法」を採用、色調、pHの変化等培地本来の性能の劣化がありません。●分包●顆粒●こちらの商品は事業者様向け商品です。
- 商品コード:
- 2500100536785
ベクトン・ディッキンソン BD Difco(TM) LBブロスミラー(Luria - Bertani) 500g 244620 1個(ご注文単位1個)【直送品】
培地
次回の入荷は未定です
●分子生物学試験で使用する大腸菌の増殖および保存用の培地です。●塩化ナトリウムを10g/L含有します。●粉末培地●用途:大腸菌用●質量:500g●こちらの商品は事業者様向け商品です。
- 商品コード:
- 2500100560292
価格: 10,552円(税込)
ベクトン・ディッキンソン BD Difco(TM) YM(イーストアンドモールド)ブロス 271120 1個(ご注文単位1個)【直送品】
培地
●酵母、真菌および他の耐酸性微生物の培養用の液体培地です。●粉末培地●用途:酵母・真菌用●質量:500g●こちらの商品は事業者様向け商品です。
- 商品コード:
- 2500100560308
ベクトン・ディッキンソン BD Difco(TM) サブローデキストロース寒天培地 500g 210950 1個(ご注文単位1個)【直送品】
培地
次回の入荷は未定です
●酵母、真菌および耐酸性微生物の培養用です。●粉末培地●局方対応●用途:酵母・真菌用●質量:500g●こちらの商品は事業者様向け商品です。
- 商品コード:
- 2500100560315
価格: 14,245円(税込)
ベクトン・ディッキンソン BD Difco(TM) ポテトデキストロースブロス 254920 1個(ご注文単位1個)【直送品】
培地
●食品および乳製品からの酵母および真菌の培養用です。●粉末培地●用途:酵母・真菌用●質量:500g●こちらの商品は事業者様向け商品です。
- 商品コード:
- 2500100560322
ベクトン・ディッキンソン BD Difco(TM) ラクトバシラスMRSブロス 500g 288130 1個(ご注文単位1個)【直送品】
培地
次回の入荷は未定です
●乳酸桿菌の培養に使用される液体培地です。●粉末培地●用途:乳酸菌用●質量:500g●こちらの商品は事業者様向け商品です。
- 商品コード:
- 2500100560339
価格: 19,171円(税込)
ベクトン・ディッキンソン BD Difco(TM) ラクトバシラスMRS寒天培地 288210 1個(ご注文単位1個)【直送品】
培地
●乳酸桿菌の分離および培養に使用される培地です。●粉末培地●用途:乳酸菌用●質量:500g●こちらの商品は事業者様向け商品です。
- 商品コード:
- 2500100560346
ベクトン・ディッキンソン BD Difco(TM) マリンブロス2216 279110 1個(ご注文単位1個)【直送品】
培地
●従属栄養海洋性細菌の培養用です。●粉末培地●用途:従属栄養細菌用●質量:500g●こちらの商品は事業者様向け商品です。
- 商品コード:
- 2500100560353
ベクトン・ディッキンソン BD Difco(TM) YPDブロス 242820 1個(ご注文単位1個)【直送品】
培地
●分子生物学で使用する酵母の増菌および保存用の液体培地です。●粉末培地●用途:保存用●質量:500g●こちらの商品は事業者様向け商品です。
- 商品コード:
- 2500100560360
ベクトン・ディッキンソン BD Bacto(TM) 寒天 1LB(454g) 214010 1個(ご注文単位1個)【直送品】
培地
●異物、着色剤、塩分を最低限に減らした精製寒天です。●淡色の細かい顆粒で使い易く、秤量、取り扱いに便利です。●通常、固体培地には1~2%濃度で、嫌気性および微好気性菌の運動性と生育検査用培地には0.05%~0.5%の濃度で使用します。●粉末培地●仕様:寒天・ゲル●重量:1LB(454g)●こちらの商品は事業者様向け商品です。
- 商品コード:
- 2500100560377
ベクトン・ディッキンソン BD Difco(TM) スキムミルク 232100 1個(ご注文単位1個)【直送品】
培地
●スプレードライ状で、この10%溶液が同量の新鮮なスキムミルクにあたります。●カゼインの凝固および蛋白分解に基づいた微生物の検出用です。●粉末培地●質量:500g●こちらの商品は事業者様向け商品です。
- 商品コード:
- 2500100560384
ベクトン・ディッキンソン BD Difco(TM) ブドウ糖トリプトン寒天培地 280100 1個(ご注文単位1個)【直送品】
培地
●食品の腐敗に関係する好温性フラットサワー菌の培養に用いる培地です。●粉末培地●質量:500g●こちらの商品は事業者様向け商品です。
- 商品コード:
- 2500100560391
ベクトン・ディッキンソン BD Difco(TM) M - FC寒天培地 500g 267720 1個(ご注文単位1個)【直送品】
培地
●ロゾリック酸( No.232281)と共に使用します。●メンブレンフィルター法による糞便中の腸内細菌の検出および菌数測定用です。●粉末培地●用途:大腸菌群用●質量:500g●こちらの商品は事業者様向け商品です。
- 商品コード:
- 2500100633507
極東製薬工業 粉末肉エキス 500g 1個(ご注文単位1個)【直送品】
培地
次回の入荷は未定です
●濃縮カツオ・動物肉抽出物●エキス●内容量:500g●有効期限:製造日より2年●こちらの商品は事業者様向け商品です。●こちらの商品は取寄せ商品となり納期が長期間かかる可能性がございます。また、ご発注後のキャンセルは対応いたしかねますので予めご了承ください。
- 商品コード:
- 2500101491618
価格: 13,510円(税込)